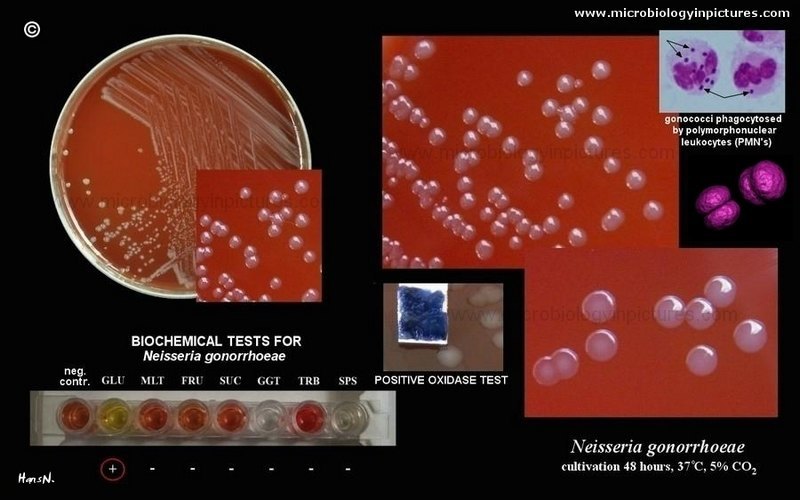
Neisseria gonorrhoeae morphology and culture - Neisseria gonorrhoeae(Image source: http://www.microbiologyinpictures.com/)

Thayer-Martin agar is a selective medium used for the isolation of gonococci (Neisseria gonorrheae) from specimens containing a mixed flora of bacteria and/or fungi e.g. urogenital specimen. Modified Thayer-Martin (MTM) agar is a GC agar base containing vancomycin, colistin, nystatin, and trimethoprim lactate (VCNT). Selective isolation of Neisseria gonorrhoeaeis achieved with suppression of most other gram-negative diplococci, gram-negative bacilli, gram-positive organisms, and yeast.
Thayer-Martin medium contains antimicrobials that inhibit the growth of organisms other than N. gonorrhoeae.
- vancomycin inhibits gram-positive bacteria,
- colistin inhibits gram-negative bacteria including the commensal Neisseria spp.,
- trimethoprim inhibits swarming of Proteus spp.,
- nystatin is an antifungal agent.
Most Neisseriastrains have complex growth requirements. Gonococci are not able to grow on common blood agar.
Media preparation
- Suspend 7.2 g of GC agar base in 100 ml distilled water in a flask. Mix thoroughly, heat with frequent agitation, and bring to a boil for 1 minute to completely dissolve the powder.
-  Autoclave the flask at 121°C for 15 minutes.
- Cool to 50°C in a water bath.
- Add 100 ml of warm distilled water to 2 g of soluble hemoglobin powder. Mix the powder with 5-10 ml of distilled water until a smooth paste is achieved. Gradually add the balance of water until the solution is homogenous. Continually stir the solution during the addition of water.  Alternatively, 100 ml ready-made 2% sterile hemoglobin solution, warmed to 50°C can be used.
- Autoclave the solution at 121°C for 15 minutes. Cool to 50°C in a water bath.
- Reconstitute lyophilized growth supplement containing NAD and hemin by aseptically transferring 10 ml of the accompanying diluent with a sterile needle and syringe. Shake to assure complete solution. After reconstitution, use immediately or store at 4°C and use within 2 weeks.
- Aseptically add 100 ml sterile hemoglobin solution and growth supplement to 100 ml of the GC agar base solution. Mix gently, but thoroughly, to avoid air bubbles in the agar.
- To the agar base solution, add the following ingredients:
3.0 µg/ml vancomycin 7.5 µg/ml colistin 12.5 units/ml nystatin 5.0 µg/ml trimethoprim lactate
- Dispense 20 ml into 15×100 mm Petri dishes. Allow the media to solidify and condensation to dry.
- Place the plates in sterile plastic bags and store them at 4°C until use.
Culture and Isolation
- Specimen (urethral or endocervical) is directly inoculated in the culture plates (swabs with plastic or wire shafts and rayon, Dacron, or calcium alginate tips is used to collect the specimen for the culture of gonococci).
- The inoculated culture plate should be promptly placed into a CO2-enriched (3%- 10%) environment and incubated at 35º-37ºC.
- Small opaque, grayish-white to colorless, raised, glistening and smooth colonies are seen.
Quality control
- Grow N. meningitidis QC strain for 18-24 hours on MTM at 35-37°C with ~5% CO2 (or in a candle jar).
- Observe the MTM for specific colony morphology.
- As a sterility test, incubate an uninoculated plate for 48 hours at 35-37°C with ~5% CO2 (or in a candle jar).
Result and Interpretations
- N. meningitidis should appear as large, round, smooth, convex, colorless-to-grey, opaque colonies on the MTM with no discoloration of the medium.
- After 48 hours, the sterility test plate should remain clear.
References
- Color Atlas and Textbook of Diagnostic Microbiology, Koneman, 5th edition
- Greenwood, J. R., Voss, J., Smith, R. F., Wallace, H., Peter, C., Nachtigall, M., Maier, T., Wilber, J., & Butsumyo, A. (1986). Comparative evaluation of New York City and modified Thayer-Martin media for isolation of Neisseria gonorrhoeae. Journal of clinical microbiology, 24(6), 1111–1112. https://doi.org/10.1128/jcm.24.6.1111-1112.1986